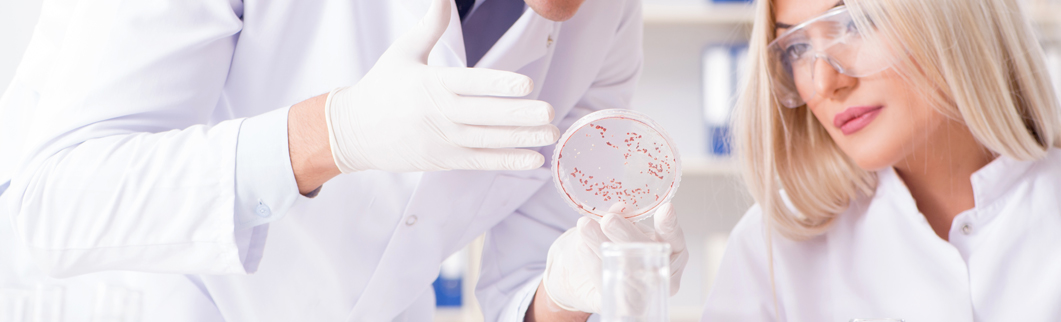
Análisis clínicos

¿Qué funciones desarrolla el farmacéutico analista?
Tradicionalmente los análisis clínicos han estado ligados a la actividad del farmacéutico y formaba parte de una de sus actividades que desarrollaba en la farmacia. Los conocimientos y habilidades se adquirían a través de cursos impartidos por las Universidades y Colegios de Farmacéuticos.
A partir del año 1982 se establece el “REAL DECRETO 2708/1982, DE 15 DE OCTUBRE, POR EL QUE SE REGULAN LOS ESTUDIOS DE ESPECIALIZACION Y LA OBTENCION DEL TITULO DE FARMACEUTICO ESPECIALISTA” quedando enmarcada dicha actividad en el ámbito de las especialidades farmacéuticas.
En la actualidad para obtener el título de “Farmacéutico Especialista en Análisis Clínicos” es necesario acceder a la vía FIR mediante una prueba de acceso y un periodo de formación es de 4 años.
Esta titulación permite acceder a puestos de trabajo en la administración pública y solicitar la autorización para la apertura de un laboratorio propio de análisis clínicos.
El farmacéutico analista se encarga de las siguientes competencias:
- Elección de las técnicas de laboratorio más adecuadas a las necesidades diagnosticas.
- La supervisión y realización de los procedimientos normalizados de trabajo de las diferentes pruebas.
- La realización de las pruebas de laboratorio solicitadas.
- Establecer los sistemas de control de calidad apropiados.
- Supervisar y validar el trabajo realizado por los técnicos de laboratorio.
- Validar los resultados obtenidos en los procesos analíticos.
- La interpretación de los resultados obtenidos y su discusión con el médico especialista correspondiente.
- Supervisar y/o realizar, según las circunstancias, de la toma de muestra.
Salidas profesionales
El Titulo de Farmacéutico Especialista en Análisis Clínicos faculta para:
- Trabajar en los centros del Sistema Nacional de Salud en el ámbito del laboratorio clínico.
- Trabajar en laboratorios de Hospitales del sector privado.
- Trabajar en laboratorios privados.
- Trabajar en laboratorios de centros de investigación.
- Ser titular de un laboratorio de análisis clínicos propio.
Información de interés
Legislación
En nuestra comunidad autónoma para poder solicitar la licencia de apertura de un laboratorio de análisis clínicos es necesario estar en posesión del título de “Farmacéutico Especialista en Análisis Clínicos y cumplir con los requisitos establecidos por el “DECRETO 157/2014, de 3 de octubre, del Consell, por el que se establecen las autorizaciones sanitarias y se actualizan, crean y organizan los registros de ordenación sanitaria de la Conselleria de Sanidad” y la “ORDEN 7/2017, de 28 de agosto, de la Conselleria de Sanidad Universal y Salud Pública” que desarrolla el anterior decreto,
http://www.dogv.gva.es/va/disposicio?sig=008836/2014&
Laboratorios

Laboratorio Dr. Carlos Sebastiá
Más información

Laboratorio pluridisciplinar que dispone de un catálogo de servicios con recursos propios, ofreciendo en la actualidad más de 300 determinaciones analíticas. Por otra parte colabora con Laboratorios de referencia para la determinación de pruebas especiales, no siendo un punto de extracción. Dispone de un servicio de consultoría personalizado y sIgue los controles de calidad de la Conselleria de Sanidad y AEFA
Servicios
CATÁLOGO DE PRUEBAS:
Hematología Bioquímica Microbiología Parasitología Inmunología Fertilidad Controles terapeúticos de coagulación Análisis hormonales y de nutrición Genética (Enfermedad celíaca, intolerancias lactosa, fructosa ....) Marcadores tumorales Screening prenatal Intolerancia alimentos Alergias alimentarias Infecciones de Transmisión Sexual Controles terapéuticos de colesterol, ácido úrico (gota), triglicéridos Controles hepatobiliares Controles de Vitaminas y Oligoelementos Determinación de sexo fetal Microbiota intestinal (Disbiosis, Candida) Marcadores intestinales Perfil de Vitaminas Perfil de Ácidos Grasos
SALUD DE LA MUJER:
Controles de anemia Perfiles tiroideos Chequeos contraceptivos Cultivos cérvico-vaginales (hongos ..) Control y cultivo de la orina Infecciones de Transmisión Sexual Determinación de sexo fetal Determinaciones hormonales Capacitación de semen para inseminación Marcadores tumorales
SALUD DEL HOMBRE:
Chequeos generales, deportivos Controles colesterol Estudios hepáticos Valoración del semen Infecciones de Transmisión Sexual Cultivos uretrales Marcadores tumorales (próstata ..)
ESTUDIANTES Y DEPORTISTAS:
El laboratorio ofrece un descuento desde un 5% - en pruebas especiales - hasta un 10% - en analíticas generales - a los titulares del Carnet de estudiante o Tarjeta Deportiva
Ofrecemos descuentos para los compañeros colegiados en el MICOF y en otros Colegios
Contacto
Pasaje Dr. Bartual Moret, 1, puerta 39.
46010-Valencia
Tfno.963693703
E-mail: carlos.sebastia@uv.es

Análisis Clínicos F.Montoliu
Más información

Servicios
Hematología, bioquímica, Hormonas, Microbiología, Genética, Enfermedades de Transmisión sexual, Pruebas de paternidad, Detección de drogas en orina y en pelo,etc. En Laboratorio Análisis Clínicos F. Montoliu encontrará un equipo profesional y experimentado que le ofrecerá servicios de análisis clínicos con la profesionalidad que se merece.
Resultados en el día: Análisis clínicos: sangre, orina, heces, esputos, esperma, exudados uretrales y vaginales, pruebas de paternidad (por DNA). HIV: en el día, confidencial anticuerpos y antígeno p24. Hepatitis: A, B y C. Marcadores de la hepatitis.
Enfermedades de Transmisión sexual (ETS): HIV/VIH: Precio 25 € Sifilis (VDRL/RPR): Precio 9 € Hepatitis B ( Ag-HBs): 15 € Hepatitis C : Precio 24 €. OFERTA: Las 4 determinaciones 50 € con el resultado el mismo día. También: Anticuerpos Chlamydia trachomatis IgG e IgM Exudado uretral / vaginal: ( buscar gonococias,Trichomonas, etc.) 24 €
TEST DE INTOLERANCIA ALIMENTARIA: ( 111 ALIMENTOS): Precio 160€
TEST DE INTOLERANCIA A LA LACTOSA: Precio: 95€ ( Previa cita)
TEST DE INTOLERANCIA A LA FRUCTOSA: Precio: 95 € ( Previa cita)
ANÁLISIS GENERAL ( Personas menores de 40 años) : Precio 45 € con los parametros: a) Hemograma con hematíes,leucocitos,Hto,Hb, Plaquetas, VSG, Formula leucocitaria, VPM, ADE b) glucemia basal c) Colesterol total d) HDL-colesterol ( colesterol bueno) e) LD-Colesterol ( colesterol malo) f) Trigliceridos g) Urea h) Creatinina i) acido urico j) Transaminasas ( GOT y GPT) l) Lactato deshidrogenasa ( LDH)
ANÁLISIS GENERAL ( Persona mayores de 40 años) : Precio 55 € con los parametros: a) Hemograma con hematíes,leucocitos,Hto,Hb, Plaquetas, VSG, Formula leucocitaria, VPM, ADE b) glucemia basal c) Colesterol total d) HDL-colesterol ( colesterol bueno) e) LD-Colesterol ( colesterol malo) f) Trigliceridos g) Urea h) Creatinina i) acido urico j) Transaminasas ( GOT y GPT) l) Lactato deshidrogenasa ( LDH) y además el PSA ( antigeno Prostatico especifico en hombres)
Contacto
Calle Cuenca,29-piso 2º-puerta 4ª
46007-Valencia
Tfno. 963846940
E-mail: f.montoliu.000@micof.es
Redes sociales

Laboratorio - Farmacia Belda
Más información

Servicios
Oficina de farmacia con multitud de servicios destinados a mejorar la salud de nuestros pacientes, entre los que se encuentran: análisis clínicos, diagnóstico capilar con microcámara, formulación magistral, atención farmacéutica, asesoramiento dermocosmético, servicios de promoción de la salud, información y educación sanitaria, punto de salud visual y punto de distribución de productos sin gluten.
Contacto
C/ Pío XII, 28 bajo
Onteniente
Tfno. 962916509
E-mail: farmaciabeldagaliana@gmail.com
Redes Sociales

LABORATORIO - FARMACIA FRANCISCO ALAMANZÓN RODRÍGUEZ
Más información

Contacto
Avenida Santos Patronos, 15
46600 Alzira,
Tfno. 962410243
E-mail: franciscoalamanzon@redfarma.org
Redes Sociales

LABORATORIO R.VALLET-M.FERNANDEZ C.B.
Más información

Laboratorio de análisis clínicos y análisis de aguas.
Servicios
Análisis clínicos ( Hematología, bioquímica, Microbiología , inmunología ...) Privados y de seguros Médicos (Asisa, Adeslas, DKV, Sanitas , Mapfre ,Hna , AXA, Salus ) y análisis de aguas.
Contacto
Avda 25 de Abril 107-1º
Cullera (Valencia)
Tfno. 961723010
E-mail: valletfernandez@hotmail.com

Laboratorio - Mª Rosario Hernández Marrero
Más información

Somos una empresa que ofrece servicios de Análisis Clínicos.
Contacto
C/ Francisco Martinez nº 2 pta 1
46020 Valencia
Tfno. 963931549
E-mail: m-marrero-v@micof.es









 Farmacias abiertas y de urgencia más cercanas
Farmacias abiertas y de urgencia más cercanas